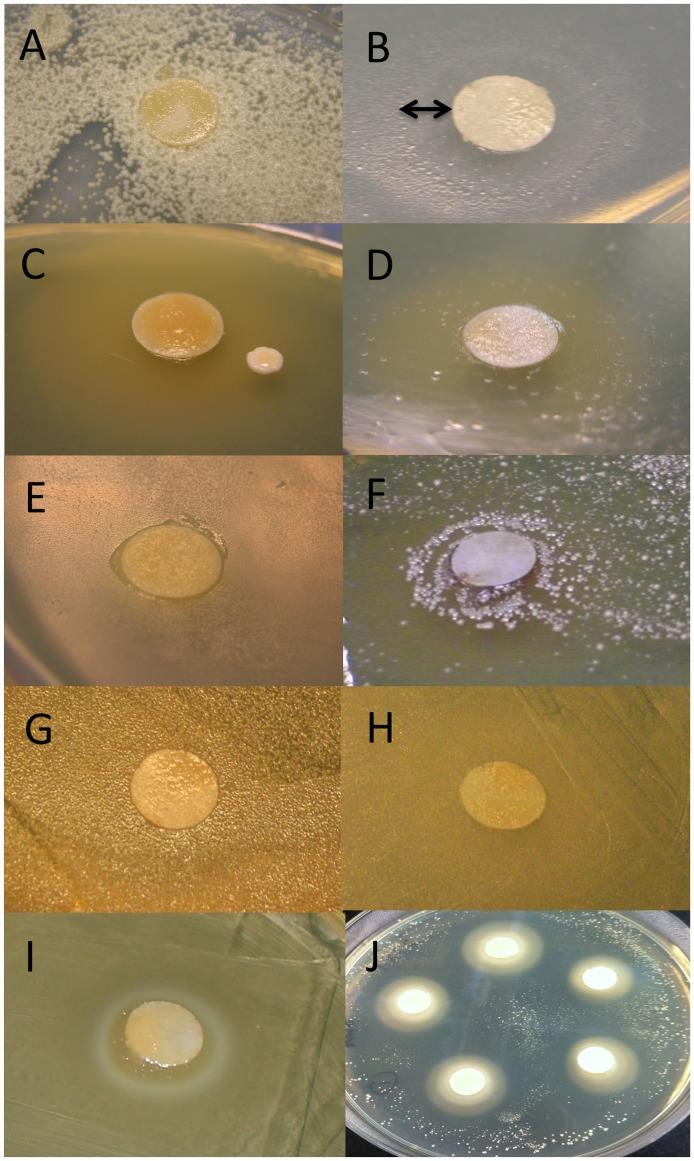
https://cdn.ncbi.nlm.nih.gov/pmc/blobs/7503/3749107/c38b6f0a241a/pone.0072106.g004.jpg

非洲化和欧洲蜜蜂幼虫期的肠道微生物多样性。
Microbial gut diversity of Africanized and European honey bee larval instars.
机构信息
Center for Insect Science, Department of Ecology and Evolutionary Biology, University of Arizona, Tucson, Arizona, United States of America.
出版信息
PLoS One. 2013 Aug 21;8(8):e72106. doi: 10.1371/journal.pone.0072106. eCollection 2013.
The first step in understanding gut microbial ecology is determining the presence and potential niche breadth of associated microbes. While the core gut bacteria of adult honey bees is becoming increasingly apparent, there is very little and inconsistent information concerning symbiotic bacterial communities in honey bee larvae. The larval gut is the target of highly pathogenic bacteria and fungi, highlighting the need to understand interactions between typical larval gut flora, nutrition and disease progression. Here we show that the larval gut is colonized by a handful of bacterial groups previously described from guts of adult honey bees or other pollinators. First and second larval instars contained almost exclusively Alpha 2.2, a core Acetobacteraceae, while later instars were dominated by one of two very different Lactobacillus spp., depending on the sampled site. Royal jelly inhibition assays revealed that of seven bacteria occurring in larvae, only one Neisseriaceae and one Lactobacillus sp. were inhibited. We found both core and environmentally vectored bacteria with putatively beneficial functions. Our results suggest that early inoculation by Acetobacteraceae may be important for microbial succession in larvae. This assay is a starting point for more sophisticated in vitro models of nutrition and disease resistance in honey bee larvae.
了解肠道微生物生态学的第一步是确定相关微生物的存在和潜在生态位宽度。虽然成年蜜蜂的核心肠道细菌越来越明显,但关于蜜蜂幼虫共生细菌群落的信息却很少且不一致。幼虫肠道是高致病性细菌和真菌的靶标,这凸显了需要了解典型幼虫肠道菌群、营养和疾病进展之间的相互作用。在这里,我们表明,一些先前在成年蜜蜂或其他传粉媒介的肠道中描述的细菌群定植在幼虫肠道中。第一和第二龄幼虫几乎仅含有先前描述过的α2.2,即核心醋杆菌科,而后期幼虫则由两种截然不同的乳杆菌属之一主导,具体取决于采样部位。蜂王浆抑制试验表明,在幼虫中存在的七种细菌中,只有一种奈瑟氏菌科和一种乳杆菌属受到抑制。我们发现了具有潜在有益功能的核心和环境载体细菌。我们的结果表明,醋杆菌科的早期接种可能对幼虫中微生物的连续定植很重要。该试验是研究蜜蜂幼虫营养和抗病性的更复杂体外模型的起点。